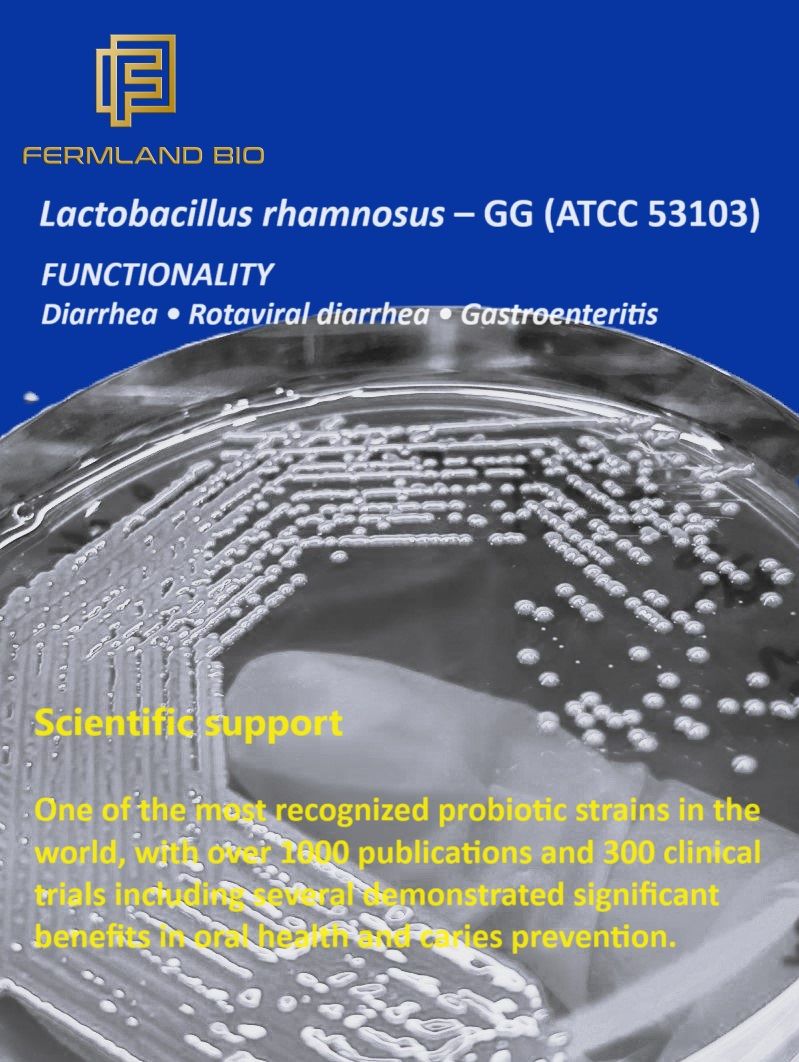

Ingredients Categories
Finished Products
Finished Food Categories
- Bakery
- Beverages / Juices
- Cereal and grain products
- Confectionery
- Cooking Fats & Oils
- Dairy
- Egg products
- Fruits & Vegetables
- Infant & Baby food
- Meat, Poultry & Fish
- Nuts & Seeds products
- Other Finished Food Categories
- Pet Food
- Plant-based foods
- Prepared foods
- Sauces & Seasonings
- Sweet & Savoury Spreads
Health & Wellness Areas
Delivery Formats
Operations & Services
- 3D printing
- Analysis/ Testing
- Auditing & certifications
- Blending & mixing
- Bottling
- Certification
- Clinical Trials
- Co-packing
- Coating
- Consulting
- Contract manufacturing
- Drying
- Electrospinning
- Encapsulating
- Enzymatic processing
- Extracting
- Extrusion
- Fat structuring
- Fermentation
- Filling
- Flavour development
- Freeze Drying
- Granulating/ grinding/ milling / mixing
- High pressure processing
- Labelling
- Other Operations & Services
- Packaging
- Packet filling
- Pasturising
- Quality assurance
- Saccharification
- Sheer cell processing
- Spray drying
- Sterilisation
- Storage & Logistics
- Tabletting
- Toasting / roasting
- Ultra-high temperature processing
Lactobacillus rhamnosus GG
Product description
Lactobacillus rhamnosus GG is a well-researched probiotic strain known for supporting digestive health, boosting immunity, and maintaining gut microbiota balance. It is widely used in dietary supplements, functional foods, and pharmaceuticals for its proven safety and efficacy.
Availability: 5 Billion CFU to 500 Billion CFU/g
Packaging: 1Kg and 5kg, Bulk 25 Kg
Read more
Availability: 5 Billion CFU to 500 Billion CFU/g
Packaging: 1Kg and 5kg, Bulk 25 Kg
Specifications
| Categories | Fungi & Yeasts, Microorganisms & Probiotics, Mushrooms | Microorganisms & ProbioticsBifidobacterium; Fungi & Yeasts, Microorganisms & Probiotics, Mushrooms | Microorganisms & ProbioticsLactobacillus; Fungi & Yeasts, Microorganisms & Probiotics, MushroomsMicroorganisms & Probiotics; Cardiovascular Health; Digestive Health; Women's Health; Dosage FormatsCapsules; Dosage FormatsPowders; Dosage FormatsSticks; Contract manufacturing |
|---|---|
| Sales markets | Western Europe; Eastern Europe; Middle East; Asia; Australia; North America; Africa; Central/South America |
| Supplied from | India |
| Certifications | Gluten-free; Halal; Health & Safety; Health claims; Kosher |
More products from Fermland Bio
Lactobacillus rhamnosus GG